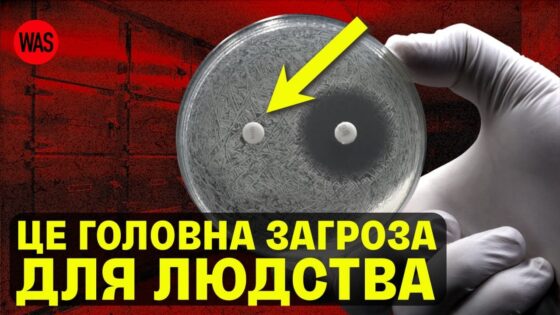

❤️TG канал Ukraine Mobile➔ https://t.me/uarpmobile
❤️Скачати гру Ukraine Mobile➔ https://uarp.mobi/start
💜Промокод➔tadashi
Отже бачу, що рубрика у якій я формую тір-лісти різних серій ігор вам більш-менш цікава, тому у сьогоднішньому відео я сформував тір-ліст ігор серії Battlefield, і це дуже актуально враховуючи те, що зовсім нещодавно вийшла нова частина серії – БФ6
Тому бажаю гарного перегляду
Одяг бренду Tur Wear зі знижкою 10% за промокодом “Tadashiwha”
https://turwear.com/?utm_source=pr&utm_medium=band&utm_campaign=tadashiwha
Підтримати канал🙏:
Спонсорство: https://www.youtube.com/@Tadashiwha/join
Банка Моно: https://send.monobank.ua/jar/78khtpMo7R
Донателло (спонсорство): https://donatello.to/tadashiwha
Мої соцмережі:
Discord – https://discord.com/invite/gwyYk9rQ3S
Телеграм – https://t.me/fuegillion
Твіч – https://www.twitch.tv/tadashiwha
Пошта для співпраці: japan170203@gmail.com
Таймкоди:
00:00:00 – Вступ
00:00:38 – BF1942
00:02:26 – BF Vietnam
00:04:47 – Battlefield 2
00:08:16 – BF2142
00:10:40 – Battlefield Bad Company
00:12:45 – BF1943 та Heroes
00:13:48 – BF BC2
00:16:45 – Battlefield 3
00:18:53 – Battlefield 4
00:22:08 – BF Hardline
00:23:41 – Battlefield 1
00:25:01 – Battlefield 5
00:27:18 – Battlefield 2042
00:30:18 – Battlefield 6
00:32:22 – Висновок
________________________________________________________________________
#ятадаші #тадаші #battlefield6 #bf6 #battlefield

Будьте першим, хто прокоментує